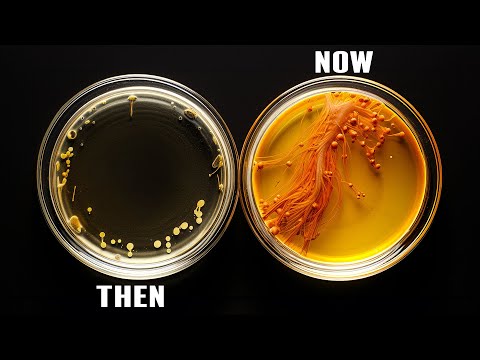

Science Journalism Is Shrinking–Along With Public Trust In Science

Last year was a tough one for science journalism. National Geographic laid off all of its staff reporters, and Wired laid off 20 people. And the most recent blow came in November, when Popular Science announced it would stop publishing its magazine after a 151-year run, and laid off the majority of its staff.
Beyond talented journalists losing their jobs, many people seem to be losing trust in science in general. A recent Pew Research Center survey found that only 57% of Americans think science has a mostly positive effect on society, down considerably since the beginning of the COVID-19 pandemic.
Is the waning trust in science reflected in the shrinking of science journalism?
Ira talks about the current state of science journalism with Deborah Blum, science journalist, author, publisher of Undark magazine, and director of the Knight Science Journalism Program at Massachusetts Institute of Technology and Sabrina Imbler, author and science reporter for Defector.
Beyond talented journalists losing their jobs, many people seem to be losing trust in science in general. A recent Pew Research Center survey found that only 57% of Americans think science has a mostly positive effect on society, down considerably since the beginning of the COVID-19 pandemic.
Is the waning trust in science reflected in the shrinking of science journalism?
Ira talks about the current state of science journalism with Deborah Blum, science journalist, author, publisher of Undark magazine, and director of the Knight Science Journalism Program at Massachusetts Institute of Technology and Sabrina Imbler, author and science reporter for Defector.

Note